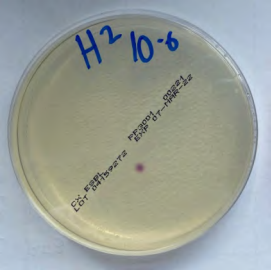
Figure 1. Resistant isolate (seen as purple-bacterial colony on petri dish) was found in faecal samples from calves fed milk replacer containing trace amounts of Neomycin and Amoxcillin

Waste milk – is it suitable to feed to calves?
A study was recently undertaken in Teagasc Moorepark to investigate the effects of feeding waste milk for either the entire pre-weaning period (12 weeks) or for two-weeks, from three to five weeks old, compared to calves fed milk replacer with no antibiotic residues.
The below was prepared by Anna Flynn, Marie McFadden and Emer Kennedy, Teagasc, Animal & Grassland Research and Innovation Centre, Moorepark, Fermoy, Co. Cork, and first published in the Moorepark 2025 Open Day Book (PDF).
When dairy cows are treated with antibiotics – often for infections like mastitis – their milk can contain drug residues and must be withheld from sale. This milk, known as waste milk (WM), is commonly fed to calves. A survey of Irish dairy farms found that over half of farmers feed WM to their calves.
Waste milk feeding (WMF) is associated with increased risks of calf diarrhoea, inflammation, and changes to gut bacteria that are important for digestion and immunity.
A major concern with WMF is the potential for calves to develop and shed antimicrobial-resistant (AMR) bacteria. These bacteria can spread within the farm and may pose a threat to both animal and human health.
Calves may act as reservoirs for AMR, especially if resistance persists as they grow older. Most research so far has only looked at short-term effects of WMF, often in indoor farming systems. A study was recently undertaken in Teagasc Moorepark to investigate the effects of feeding WM for either the entire pre-weaning period (12 weeks) or for two-weeks, from three to five weeks old, compared to calves fed milk replacer with no antibiotic residues.
Summary
- Waste milk feeding did not impact growth, but led to increased antimicrobial resistance in young calves
- Calf growth and general health remained unaffected, but gut health showed some negative post-weaning impacts
- Waste milk feeding duration should be limited and high standards of hygiene maintained to reduce resistance spread on farms
Results
There was no difference in calf weights or average daily gain pre-weaning, at weaning or post-weaning.
All calves in the study received good-quality colostrum, and passive immunity was similar across all treatment groups. Overall health was high throughout the study, with most calves showing no signs of illness before, during, or after weaning. During the pre-weaning period, calves fed WM throughout showed slightly better health than those not offered WM at any point. However, faecal scores, used to assess gut health, after weaning were higher in calves fed WM when they were three to five weeks old. There were no big differences between groups in indicators of respiratory issues like cough or nasal discharge. Overall, feeding WM had limited effects on visible calf health. Antimicrobial-resistant bacteria were found on staff boots and feeding equipment used for calves fed WM (Figure 1), but not on gloved hands or pen floors. All calf groups had resistant bacteria in their faeces, with higher levels in those fed WM, especially early in life, raising concerns about resistance spread.
The study showed that feeding WM affected the gut bacteria of calves over time. Calves fed WM had bacteria with more antibiotic-resistant genes, but these decreased over time. Although the total number of species stayed highest in the control group, key differences in specific bacteria and metabolic activity were seen. Waste milk feeding may influence gut development and increase antimicrobial resistance, especially during early growth stages.
Discussion
To minimise risks linked with feeding WM, farmers should consider a few key recommendations. Firstly, ensure WM is low in antibiotic residues (day three post-treatment onwards), as even low levels can influence calf gut health and encourage AMR. While WM did not affect calf growth rates, it may still disrupt gut microbiota, especially during stressful periods like weaning – so close monitoring of calf health is essential. Given that calves fed WM shed higher levels of resistant bacteria early in life, good hygiene is recommended to reduce AMR spread on farm. Finally, since microbial changes and resistance appear to decline post-weaning, limiting the duration of WM feeding and transitioning to antibiotic free feed early may help reduce long-term risks.
Figure 1. Resistant isolate (seen as purple-bacterial colony on petri dish) was found in faecal samples from calves fed milk replacer containing trace amounts of Neomycin and Amoxcillin
Conclusion
Feeding WM did not affect calf growth or overall health but led to looser faeces at weaning and post-weaning. More importantly, WM feeding contributed to the emergence of antimicrobial resistance. Feeding WM may alter the development of the faecal microbiota, though the downstream implications of this remain unclear. These findings highlight potential risks, suggesting that farmers should avoid or limit feeding waste milk to calves whenever possible.
Acknowledgements
This research is funded by Taighde Éireann – Research Ireland and the Department of Agriculture, Food and Marine on behalf of the Government of Ireland under Grant Number [21/RC/10303_P2] – VistaMilk.
For more insights on the research carried out at Moorepark, access the Moorepark 2025 Open Day Book (PDF) here.
